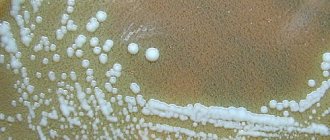

Composition and principle of action More advanced anti-inflammatory drugs appear on the market every year.
Types of rat poison and the mechanism of action on the human body Rat poison is common
Diet of adult wasps The feeding habits of larvae and mature individuals are different. This need is explained
Method of use 1. Wash your hair with regular shampoo. It is not recommended to use conditioner or combined shampoo and conditioner.
To paraphrase the famous saying, we can say that the person who has tamed the animal is responsible for its further
Storage containers Many people do not know whether it is possible to store dried fruits in plastic or rag
What is tularemia? Tularemia is an infectious disease. Both humans and animals can become infected.
Description The bread ground beetle is one of the most common representatives of the order of Coleoptera insects, which make up the most
Brief information Name in Latin: Messor structor Difficulty: for beginners Size of individuals: M -
Composition and mechanism of action Cockroach ram is available in the form of a milky liquid with